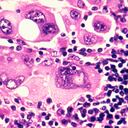
El cáncer metastásico acaba con muchas vidas en el mundo.

El café es considerada la bebida más consumida en el mundo, suele ser parte de la dieta diaria de millones de personas que beben café ya sea en la mañana, tarde o hasta en la noche. A pesar de su delicioso sabor, además de los beneficios que puede entregar, el consumo excesivo de café trae sus consecuencias.
Según un estudio realizado por la Universidad de Cambridge, el café sería un detonante de enfermedades que están relacionadas con la salud mental dentro de las que se encuentra el estrés y los trastornos de sueño.
Además, el consumo excesivo de café puede estar relacionado con problemas cardiacos a largo plazo como por ejemplo la insuficiencia cardiaca, así lo explica el portal Fit Guru.

“Piensa un poco en tus síntomas cuando has tomado más cafeína de la cuenta: manos temblorosas, ritmo cardiaco acelerado y esa sensación de nerviosismo recorriendo tu cuerpo. Beber mucho café puede incidir en tu estado de ánimo”, explica.

El café es una de las bebidas más utilizadas por las personas para activar su cerebro y poder eliminar la sensación de somnolencia y sueño, ya que ayuda a incentivar las moléculas de alerta en el cuerpo.
De acuerdo con el portal Café Mama Same, la cafeína es el principal compuesto activo del café que estimula la actividad cerebral y mantiene despierta a una persona porque bloquea los receptores de adenosina que se adhieren al cerebro indicándole que tiene sueño.
Por esta razón, de acuerdo con Caffeine Informer, cuando una persona toma una taza de café, tarda entre 15 y 20 minutos para sentir el efecto de la misma.
Si bien el cuerpo inicia la absorción inmediatamente, se tarda en sentir el efecto de alerta poco más de 15 minutos mientras pasa por el tejido epitelial como el revestimiento de la boca, la garganta y el estómago.

Además, un estudio del Centro Nacional de Información Biotecnológica aseguró que, en promedio, el efecto de la cafeína dentro del cuerpo tarda un total de 5,7 horas. Luego de este tiempo, se metaboliza y el efecto desaparece casi de inmediato.
¿Qué bebidas pueden sustituir al café?
1. Bebidas vegetales. Antes de iniciar el día, los expertos aconsejan consumir las bebidas vegetales, pero importante validar que la bebida no tenga azúcar añadida. Estas son las alternativas más frecuentes que se pueden implementar: de almendra, avellana, coco, soja, arroz y avena.
2. Jengibre con limón y miel. A pesar de que el jengibre tiene un sabor bastante fuerte e insípido, cuando se combina con miel y limón resulta una bebida deliciosa y muy útil para iniciar el día. Cabe destacar que el limón aporta vitamina C, la miel, vitaminas B, C y D y el jengibre contiene propiedades antiinflamatorias, antioxidantes y depurativas. Solamente se debe cortar varias rodajas de jengibre, hervirlas durante 15 minutos y añadir el zumo de limón y una cucharada de miel.

3. Cacao. Como tal, el cacao contiene antioxidantes, teofilina y teobromina que ayudan a que el cuerpo se mantenga activo. Sin embargo, suele ir mezclado con azúcares, por lo que es necesario cuidar su consumo. Una buena opción es consumir cacao puro sin azúcares, este puede tener un sabor amargo característico y se puede tomar con leche.
4. Té de regaliz. Esta planta medicinal se caracteriza por su alto contenido en vitamina C y minerales como el calcio, el fósforo, el hierro, el potasio y el sodio. Normalmente, las personas utiliza esta infusión para tratar los problemas digestivos gracias a sus propiedades antiinflamatorias. Adicional a ello, es un poderoso energizante para iniciar el día.
5. Té de rooibos. El rooibos es una hierba que proviene de Sudáfrica y se puede obtener por la fermentación de un arbusto rojo que le da su color. Esta infusión contiene hierro, calcio, potasio y poderosos antioxidantes que ayuda a estimular el sistema inmunológico para así protegerse contra distintas enfermedades.
